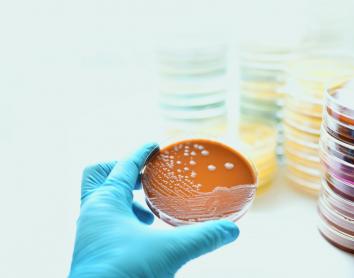
Superbacteris: Com podem afrontar una de les amenaces més grans per a la salut global?

- Imágenes
Una conferència sobre el cicle de la dona i la justícia menstrual al Palau Macaya
El dimecres 17 de juny el Palau Macaya de la Fundació "la Caixa", Centre Internacional de Ciències Humanes i Socials auspiciat per la UNESCO, acull la conferència Una nova regla. Tancament i presentació de propostes, sessió de cloenda del cicle ...
Llegir-ne més